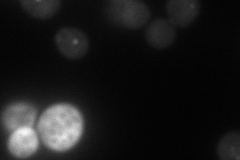
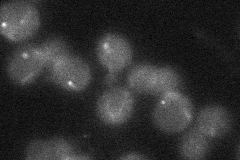
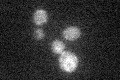

View description
Adapter protein for pexophagy and the cytoplasm-to-vacuole targeting (Cvt) pathway; directs receptor-bound cargo to the phagophore assembly site (PAS) for packaging into vesicles; required for recruiting other proteins to the (PAS)
Localization:
Intensity:
Fold change:
Significance:
-
C’ GFP library in SD

punctate18.59 -
N' NOP1pr-GFP in SD

punctate59.2288 -
N' TEF2pr-mCherry in SD
punctate61.68 -
N' NATIVEpr-GFP in SD
punctate21.1449 -
N' TEF2pr-VC and Cyto-VN in SD

punctate38.8284 -
C’ GFP library in SD+DTT

technical problem0N/ANo -
C’ GFP library in SD+H2O2

punctate23.31.25No -
C’ GFP library in Starvation Media
punctate18.91.01No -
C’ GFP library on the background of Pup2-DaMP

punctate -
C’ GFP library on the background of CCT mutant

punctate20.12541.08251No
